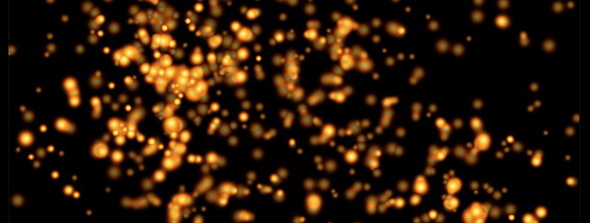

Бесплатные огненные текстуры
9 мая 2016 | Опубликовано в графика | 2 Комментариев »
 Пополняем вашу коллекцию бесплатных текстур. На этот раз мы собрали вместе яркие горящие текстуры, которые часто нужны дизайнерам при создании фото- и текстовых эффектов. В нашей подборке вы найдете и жаркий огонь, и игривые языки пламени, и всевозможные искры, и даже тлеющий костер. Переходите по ссылке, скачивайте и пользуйтесь на здоровье.
Пополняем вашу коллекцию бесплатных текстур. На этот раз мы собрали вместе яркие горящие текстуры, которые часто нужны дизайнерам при создании фото- и текстовых эффектов. В нашей подборке вы найдете и жаркий огонь, и игривые языки пламени, и всевозможные искры, и даже тлеющий костер. Переходите по ссылке, скачивайте и пользуйтесь на здоровье.

https://www.flickr.com/photos/corpmjo/4500535651/sizes/l/in/pool-580502@N21/

https://www.flickr.com/photos/malavoda/3930884815/sizes/l/




Подборка — Дежурка
Смотрите также:





